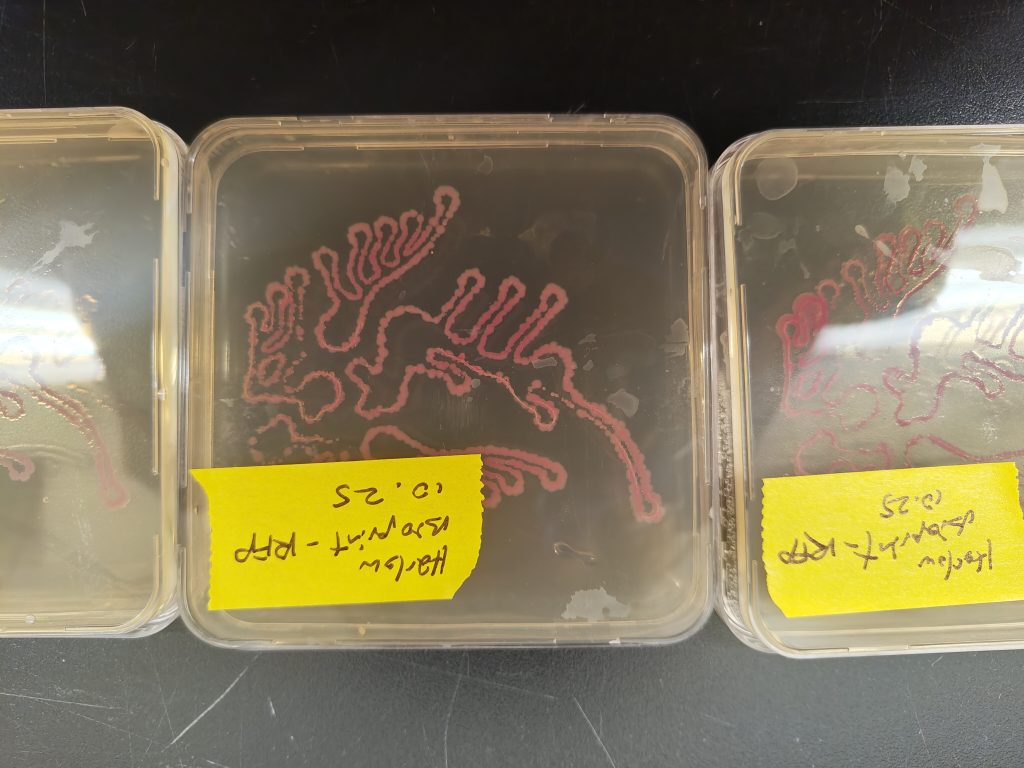
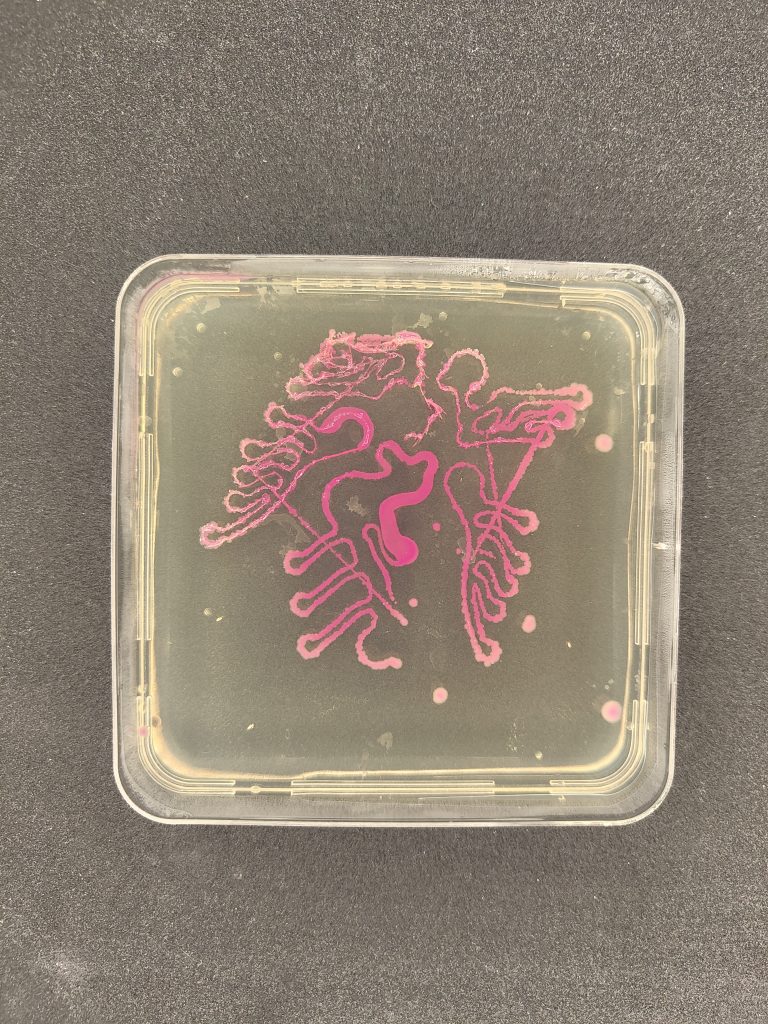
Image gallery image

Harlow Robinson Green, ESJ, 2025
Biodesigner and Multi-media artist.
Project Overview
RFP producing E. coli bioprinted onto LB kanamycin plates. Plates were grown for 2 days prior to these photos. Linework was designed on rhino, using a visual language of nodes and connections. Inspired by circuit boards and bodily systems.

Process
It took took 2 cases of LB kanamycin plates to get results I was happy with. I poured these plates following lab protocol, additionally pouring 4 plates with a several month old charcoal LB media. After making the design on Rhino and formatting it using Grasshopper, I used the laser cutter to cut my design into plastic film, using an atomizer to mist liquid culture onto 4 plates. I misted by spraying in a sterile perfume bottle with 4 sprays. I used my own samples of Orange GMO E. coli (183143) and Purple GMO E. coli (183139). I let this incubate with the stencil on top for 3 days. I was unable to remove stencil without pulling up cell growth. Nothing grew on charcoal plates. Color did not express well.
For batch 2 I used Orange GMO E. coli (183143), misting with 3 sprays, on LB kanamycin plates. On one plate, I removed the stencil immediately, and for the two others i left on top of agar. I let this grow for 1 day before returning and removing stencil. Colonies remained on the plate somewhat, though the action of removing stencil smeared them. No satisfactory color expression.
I gave up on the stencil method and switched to the bioprinter. Linework was made into code using Rhino, and printed onto plates using Ryan’s toothpick method. Plates were not particularly level, so the printer dug into the agar at points, or lifted off the surface. I applied hand pressure onto printer bed to accommodate for this.
Learn More
www.trouser.org/harlow




